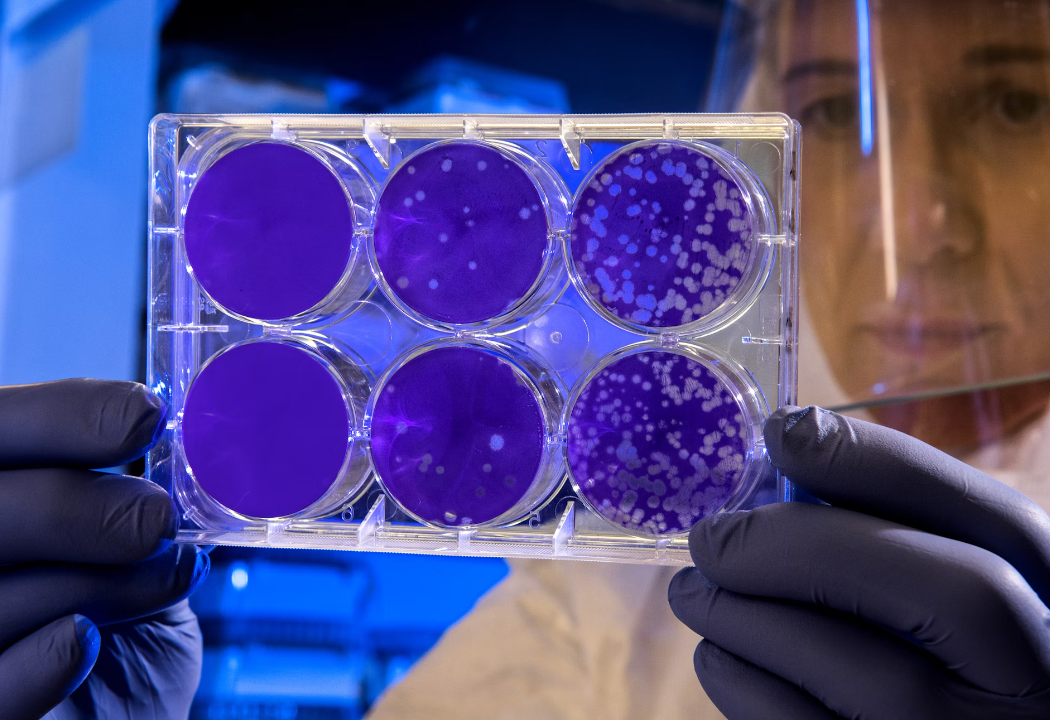
줄기세포

소개
생명윤리는 끊임없이 진화하는 생물과학과 의학의 지형에서 과학 발전이 야기하는 도덕적 딜레마를 통해 전문가와 사회 전반을 이끄는 나침반 역할을 합니다. 유전공학, 의료 분야의 인공지능, 줄기세포 연구의 무한한 가능성을 더 깊이 들여다볼수록 생명윤리의 중요성은 그 어느 때보다 두드러집니다. 이 블로그는 이러한 발전과 관련된 복잡한 도덕적 문제를 조명하고 사회, 개인의 권리, 과학계의 윤리적 책임에 대한 의미를 탐구하고자 합니다. 유전자 변형, 의료 분야의 AI, 줄기세포 연구 등 세 가지 중요한 영역을 자세히 살펴봄으로써 현대 생물과학과 의학을 규정하는 복잡한 윤리적 지형을 탐색할 것입니다.
유전자 변형: 자연의 경계를 재정립하다
CRISPR-Cas9와 같은 유전자 변형 기술의 출현은 의료, 농업, 환경 관리에서 전례 없는 가능성으로 문을 열었습니다. 그러나 이러한 발전은 윤리적인 측면에서 많은 것들과 함께 옵니다. 주요 관심사 중 하나는 유전자 변형 유기체의 장기적인 생태학적 및 건강 영향에 관한 것입니다. 예기치 않은 결과의 가능성은 수천 년 동안 진화해 온 자연 유전자 서열을 변경하는 지혜에 대한 의문을 제기합니다.
게다가, 인간의 DNA를 편집하는 능력은 아기를 디자인하는 윤리, 신체적인 그리고 인지적인 능력을 바꾸는 것, 그리고 사회적 불평등에 대한 영향에 대한 논쟁을 야기합니다. "디자이너 아기"의 전망은 자연적인 인간 발달의 개념에 도전할 뿐만 아니라, 유전적인 향상을 감당할 수 있는 사람과 그렇지 않은 사람 사이에 분열을 만들어 잠재적으로 새로운 형태의 사회적 불평등과 차별을 야기할 위험이 있습니다.
이 부분에서는 자연 생물 형태의 완전성을 훼손하거나 사회적 격차를 악화시키지 않으면서 과학자들의 작업이 인류에게 이익이 되도록 해야 할 책임을 논의하면서 유전자 변형으로 인한 윤리적 문제를 살펴봅니다.
의료 분야의 AI: 혁신과 개인 정보 보호의 균형
인공지능(AI)은 진단 정확성, 치료 개인화 및 환자 치료 효율성에 대한 혁신을 제공하면서 의료 산업에 혁명을 일으켰습니다. 잠재력에도 불구하고 의료에 AI를 통합하면 특히 환자 개인 정보 보호 및 민감한 데이터의 보안과 관련하여 윤리적으로 상당한 우려가 제기됩니다. AI 알고리즘을 사용하려면 방대한 양의 개인 건강 정보를 수집해야 하며 데이터 침해 및 오용의 위험이 있습니다.
또 다른 윤리적 고려 사항은 AI 시스템의 투명성과 책임성입니다. 일부 AI 알고리즘의 "블랙박스" 특성은 의사 결정이 어떻게 이루어지는지 이해하기 어렵게 만들어 환자 치료에 잠재적인 편견과 오류를 초래할 수 있습니다. 이러한 불투명성은 정보에 입각한 동의 원칙과 환자가 치료 결정의 근거를 이해할 권리에 도전합니다.
이 섹션에서는 AI 기반 의사 결정 프로세스에서 환자 개인 정보 보호, 데이터 보안 보장, 투명성 및 책임 유지의 중요성을 강조하면서 의료에 AI를 통합하는 윤리적 과제를 살펴봅니다.
줄기세포 연구: 약속과 위험의 탐색
줄기세포 연구는 쇠약해지는 질병을 치료하고 손상된 조직을 재생하여 전 세계 수백만 명의 환자들에게 희망을 제공할 것을 약속합니다. 하지만 배아 줄기세포의 사용을 둘러싼 윤리적 논란은 격렬한 논쟁을 불러일으켰습니다. 연구 목적을 위한 배아의 파괴가 생명의 존엄성을 침해한다고 반대하는 사람들과 함께 중심적인 문제는 배아의 도덕적 지위에 있습니다.
반대로, 지지자들은 고통을 완화하고 의학 지식을 향상해야 할 윤리적 의무를 강조하면서, 줄기세포 연구의 잠재적인 생명을 구할 수 있는 이점을 지지합니다. 줄기세포의 원천까지 논쟁의 대상이 되며, 성체 및 유도만능 줄기세포와 같은 대안은 윤리적으로 논쟁의 여지가 적지만, 그 자체로 한계와 도전이 있습니다.
이 부분에서는 줄기세포 연구의 윤리적 지형을 살펴보고, 배아줄기세포 사용에 대한 도덕적 주장과 반대 의견을 저울질하며, 윤리적 경계를 넘지 않고 의학을 발전시키는 대안적 원천의 가능성을 고찰합니다.
결론
생명윤리는 생물학, 의학, 도덕의 교차점에 서서 과학적 진보의 결과에 대해 깊이 생각해 볼 것을 요구합니다. 유전자 변형, 의료 분야의 인공지능, 줄기세포 연구의 윤리적 차원을 들여다보면, 이러한 문제들은 본질적으로 과학이나 의학에 국한된 것이 아니라 사회로서 우리의 가치에 근본적인 관심사임이 분명해집니다. 앞으로 나아갈 길은 혁신을 수용하면서도 윤리적 원칙을 지키고 생물과학과 의학의 발전이 우리의 도덕적 진실성을 훼손하지 않으면서 더 큰 이익에 기여할 수 있도록 하는 균형 잡힌 접근이 필요합니다. 이러한 복잡한 윤리적 지형을 헤쳐나가는 데 있어 과학적 진보를 인간의 가치와 일치시키기 위해서는 지속적인 대화와 포용적 정책 수립, 그리고 책임 있는 연구 수행이 필수적입니다.